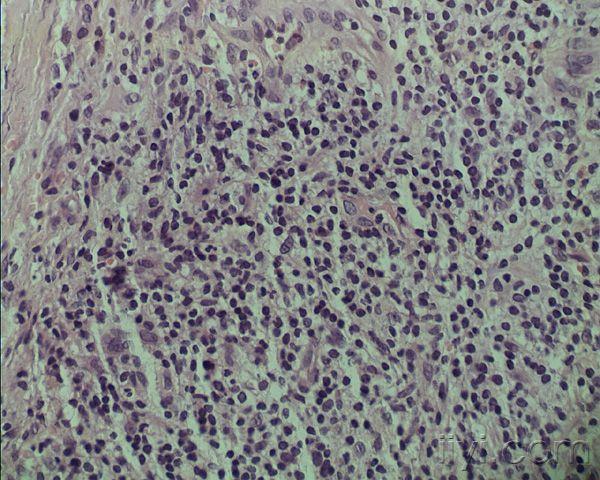
臀部皮肤病如何诊断?

屁股上的皮肤病
2022-03-02 来源:动态图库网

我儿子的屁股不知道得了什么皮肤病,他说有时候很痒,应该用点什么药?
首页 皮肤性病科 皮肤科 附件
这是什么皮肤病啊,就是痒 非常痒晚上在被窝里就更痒了,求大神告知啊
屁股上面长了一些不懂是什么的东西有红色一块块的坐久了有点
背部,大腿,屁股上会出现这种.请问是什么皮肤病?
下面青岛皮肤病研究院带大家了解下
不需要那么金贵的~不难受就不用管 追问: 我还以为是什么皮肤病
关于孩子的皮肤病,大家认识多少呢
赞果抗皮肤病
我皮肤屁股及以上部分都是这种皮肤这是什么皮肤,怎能
是皮肤病吗?医生?
首页 皮肤性病科 皮肤科
这是皮肤病是什么类型的 怎么去治 2014-02-21 靳伟 副主任医师 屁股
臀部皮肤病如何诊断?
皮肤病 您好,我家狗狗前天晚上突然开始舔屁股(尾巴
臀部皮肤病如何诊断?